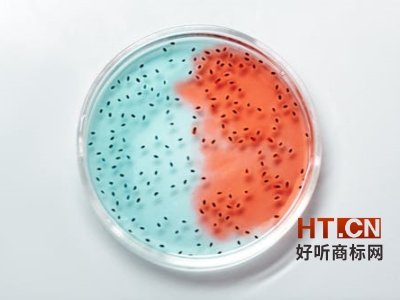
商标转让

好听网商标网讯 加多宝不是王老吉?随着2014年12月19...您还可阅读:商标权商标维权商标驳回复审假冒注册商标红罐之争,加多宝是不是王老吉呢?

好听网商标网讯 加多宝不是王老吉?随着2014年12月19日,加多宝、王老吉的红罐外包装装潢权对诉案在广东高院一审宣判。广东加多宝饮料食品有限公司被判构成侵权,加多宝不是王老吉最终尘埃落定。因此,广药集团要求广东加多宝饮料食品有限公司立即停止生产并销售与王老吉红罐凉茶包装装潢相似或相同包装的产品;赔偿广药集团1.5亿元及维权费26万余元。至此,历经19个月的“红罐之争”的较量终于以广药完胜告终。 随着判决结果的公布,网上的人们对王老吉商标争夺战却有两种截然不同的反应,一种态度是认为广药终于获得了原本就属于自己的胜利,可喜可贺;另一种态度则觉得广药在坐享其成,加多宝辛苦经营的商标和利益却被广药夺走了。然而事实真的是这样吗?
首先,我们来了解一下王老吉和加多宝产生纠纷的3大原点:
1、加多宝是不是王老吉,引商标之争
王老吉商标为何被广药收回?这要从一桩行贿案说起:
1995年,羊城药业把“王老吉”的使用权租借给加多宝的母公司鸿道集团,并规定其生产经营红色罐装和红色瓶装王老吉凉茶。1996年广药集团成立,王老吉的商标所有权也按有关规定划给了广药集团。
2000年5月3日,作为王老吉商标的持有者,广药集团与鸿道集团签署了正式合同,约定香港鸿道集团对“王老吉”商标的租赁期限为2000年5月至2010年5月,共10年。
但是,就在此后的2002年至2003年间,鸿道集团又与广药集团签署了两份补充协议,在原租赁期未满之前将商标租赁时限分别延长至2013年和2020年。也就是在两份补充协议签订期间,鸿道集团董事长陈鸿道曾行贿广药集团原总经理共300万港币,陈鸿道则保释外逃至今未归案。
也就是说广药和鸿道集团所签订的王老吉的租赁时限至2013年和2020年的补充协议均是发生在签约双方行贿、受贿基础之上的,随后2012年5月9日,中国国际贸易仲裁委员会裁决,《“王老吉”商标许可补充协议》和《关于“王老吉”商标使用许可合同的补充协议》无效,责令加多宝母公司鸿道集团停止使用“王老吉”商标。
而此时,行贿的陈鸿道已经保释外逃,在无可奈何之下,广药才选择诉诸法律手段,加多宝是不是王老吉,最终收回了王老吉的商标。
2、加多宝是不是王老吉,红罐之争誓死捍卫商标专用权。
红罐之争也正是此案被称为“中国包装装潢第一案”的关键所在。究竟是谁拥有红罐凉茶的知识产权呢?
在庭审中,加多宝代理律师称凉茶红罐包装由加多宝母公司鸿道集团董事长陈鸿道设计,并于1997年申请专利,加多宝对红罐拥有装潢权。
针对这一点,我也做了一些详实的调查,其实早在王老吉被授权给鸿道集团生产销售之前,王老吉已经是知名品牌,且其在《商标使用许可合同》中,明确约定授权鸿道生产经营红色罐装、红色瓶装王老吉凉茶。此外由于陈鸿道弃保外逃,无法对证,他设计专利这一说法并不能让人信服。
另外鸿道集团作为商标租赁方,绕过商标所有者广药直接申请外观设计专利,这种行为并不合法。并且,专利的有效期是十年,加多宝所提供的红罐专利设计证书上的专利已经过期,没有法律效力。
由此可见,红罐之争,广药胜在法理,加多宝是不是王老吉再次证明加多宝大势已去。
然而这场被称为“中国包装装潢第一案”的红罐之争,其意义远不止于胜负,更是在增强企业知识产权保护意识方面,有着极为鲜明的教育意义。
3、加多宝是不是王老吉,人心之争昭然若是。
在人心之争这一点上,两年多来,广药的营销和品牌宣传也逐渐到位。而其先天的优势在于王老吉的民族传承与基因。作为中华老字号品牌,王老吉比在英属维京群岛注册的外资企业加多宝更具民族情结。
此外,加多宝的营销太“过激”,太“犀利”也暴露了他的弱点——2012年6月,在广药拿回商标,正式推出王老吉红罐凉茶之际,加多宝在全国铺天盖地的进行“王老吉改名为加多宝”、“全国销量领先的红罐凉茶改名为加多宝”等广告宣传。
2013年3月加多宝推出“中国每卖10罐凉茶,7罐加多宝”的新版广告。
2013年5月加多宝推出了新的配方广告,自称凉茶创始人王泽邦第五代玄孙的王健仪,称其将配方独家传授给加多宝。
显然加多宝这家外资企业在自己的品牌包装和宣传上都做得非常“病毒”,展现了其借王老吉上位的野心。加多宝以上的这些宣传,除了王健仪案立案未判外,其他广告都被法院裁定为加多宝实施了虚假宣传、误导消费者的行为。这一点足以说明加多宝在争夺人心的过程中有着太多既不合法又不合理的行为。而公道自在人心,加多宝是不是王老吉,失了公道也就失了人心。尽管广药和加多宝之争暂且告一段落,我仍然希望关注这个案子的企业家和创业者们都能从中获得一些启发和警醒。如果您想了解更多加多宝是不是王老吉的商标案例,欢迎您登陆好听网商标网官网在线查阅!
更多王老吉商标之争内容资讯尽在http://www.ht.cn/special/wanglaoji/点击查阅
好听商标网在此声明:该文章内容转载自网络,目的是服务于好听商标网用户,让其获取更多更全的关于商标知识与信息。版权归原作者所有,我们尊重原创并饱含敬意。若有不妥,请联系告知修改或删除,谢谢。